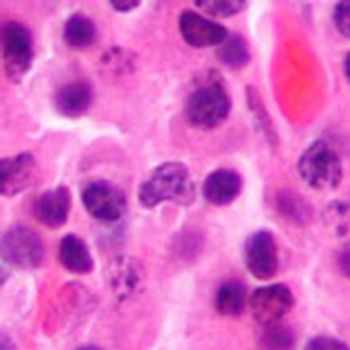

Combination pembrolizumab (Keytruda), pomalidomide (Pomalyst), and dexamethasone shows benefit for patients with relapsed/refractory multiple myeloma.
Combination pembrolizumab (Keytruda), pomalidomide (Pomalyst), and dexamethasone shows benefit for patients with relapsed/refractory multiple myeloma.
Mikel Ross discusses scalp cooling and how this treatment is changing the landscape for chemotherapy-induced alopecia.
The US House of Representatives has passed the 21st Century Cure Act which allots funding to NIH, FDA, the Cancer Moonshot and other health initiatives.
Karen Lee discusses the managment of immune-related adverse events in patients who are receiving immunotherapy treatments.
Bonnie J. Addario Lung Cancer Foundation and American Lung Associate have teamed up to create a lung Cancer Registry to connect patients with lung cancer with opportunities to support research and engage with others in the community.
Patients with cancer can be vulnerable to to caregiver abuse and should know the warning signs.
Nonburning sun exposure is associated with a reduced risk of melanoma, while sunburns are associated with a doubling of the risk of melanoma
Somatostatin analog lanreotide (Somatuline Depot) is being considered for patients with lung neuroendocrine tumors (NETs) in a potentially practice-changing clinical trial.
While palliative care interventions improve patients' quality of life, there is no survival benefit.
Kathy LaTour shares her holiday experience with cancer and the tips she's learned since.
Recent research highlights the unmet psychological needs for older breast cancer survivors.
While many oral therapies are used to treat multiple myeloma, nonadherence to oral anticancer agents continues to be a challenge.
Aside from the approved nivolumab, other immunotherapy combinations are being considered for Hodgkin lymphoma.
Optune, a noninvasive device that delivers tumor-treating fields to the brain, had been found to improve efficacy compared to chemotherapy and is well-tolerated by patients with glioblastoma multiforme (GBM).
FDA has given approval for daratumumab triplet therapy for patients with relapsed multiple myeloma
With the numbre of deaths from heart disease decreasing and the number of deaths increasing, the CDC predicts that cancer will become the leading cause of death in the US around 2016.
Members of the IHadCancer community give their insghts on what friends and family should know when sharing the holidays with a patient with cancer.
Vitamin D in women with breast cancer has been linked to a better prognosis, especially for women who are premenopausal.
Due to a dramatic reduction of risk for cervical cancer in women who have received the HBV vaccine, there may be a reduction of screening for those women.
Expert Kristin Zorn, MD discusses the importance that genetics plays in oncology, and the why genetic counseling and testing are vital.
Screening for distress, which effects 60% of patients with cancer, improve confidence in nurses and other clinicians about their ability to deliver personalized cancer care.
In order to prevent near fatal intrathecal administering of vincristine, the NCCN has launched a campaign "Just Bag It." This campaign pushes for vincristine to be stored in IV drip bags to ensure vincristine is only administered intravenously.
Richard Gralla, an expert in chemotherapy-induced nausea and vomiting (CINV), discusses how to best manage CINV in patients, including the importance of following guidelines.
Older patients with diffuse large B-cell lymphoma (DLBCL) often have an increased risk of treatment-related morbidity and mortality, but the use of preventive interventions, such as granulocyte colony-stimulating factor (G-CSF) may help.
Non-lump and non-breast symptoms of breast cancer occur for 1 in 6 women with breast cancer. For those women, patient intervals to a diagnosis of breast cancer were 1.5 times and 2 times longer.
The incidence of hepatocellular carcinoma (HCC) in patients with hepatitis B is still on the rise, making screening and surveillance in this population all the more important.
Sherry Soeder, CNP, offers practical suggestions for better survivorship care that follow the standards of care from the Comission on Cancer.
Neoadjuvant chemotherapy (NACT) in treating advanced ovarian cancer has brought improvement s to quality of life and morbidity, but there are still issues within its use, such as choosing the best candidates.